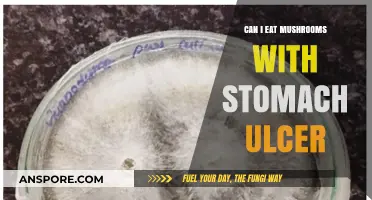
Stomach Ulcers and Mushrooms: Safe to Eat or Risky Choice?

Enoki mushrooms, known for their delicate texture and mild flavor, are a popular ingredient in many Asian cuisines. While they are commonly cooked in soups, stir-fries, and salads, some people wonder whether they can be eaten raw. The answer is yes, enoki mushrooms can be consumed raw, but there are a few considerations to keep in mind. Raw enoki mushrooms retain their crispness and can add a refreshing element to dishes like salads or as a garnish. However, it’s important to ensure they are thoroughly cleaned to remove any dirt or debris, as they are often grown in soil. Additionally, while raw consumption is generally safe, cooking them can enhance their digestibility and reduce the risk of any potential contaminants. Always source enoki mushrooms from reputable suppliers to ensure freshness and quality before enjoying them raw.
| Characteristics | Values |
|---|---|
| Edibility Raw | Yes, enoki mushrooms can be eaten raw. |
| Texture | Crisp and tender when raw. |
| Flavor | Mild, slightly sweet, and nutty. |
| Nutritional Value | Low in calories, rich in vitamins B and D, and minerals like potassium and phosphorus. |
| Safety | Generally safe to eat raw, but ensure they are fresh, clean, and sourced from a reputable supplier to avoid contamination. |
| Culinary Uses | Commonly used raw in salads, sandwiches, and as a garnish. |
| Storage | Best stored in the refrigerator and consumed within a week for optimal freshness. |
| Washing | Rinse gently under cold water before consuming raw to remove any dirt or debris. |
| Allergies | Rare, but some individuals may have allergies to mushrooms, including enoki. |
| Cooking Alternative | Can also be cooked to enhance flavor and texture, but raw consumption is safe and popular. |
Explore related products
What You'll Learn
- Nutritional Value: Raw enoki mushrooms retain vitamins, minerals, and antioxidants, offering health benefits when consumed uncooked
- Safety Concerns: Ensure enoki mushrooms are fresh and clean to avoid potential bacterial or parasitic risks
- Texture & Taste: Raw enoki has a crisp texture and mild flavor, ideal for salads or garnishes
- Preparation Tips: Rinse thoroughly, trim ends, and pat dry before adding to raw dishes
- Cooking vs. Raw: Cooking enhances umami but reduces certain nutrients; raw preserves enzymes and freshness

Nutritional Value: Raw enoki mushrooms retain vitamins, minerals, and antioxidants, offering health benefits when consumed uncooked
Raw enoki mushrooms are a nutritional powerhouse when consumed uncooked, preserving their full spectrum of vitamins, minerals, and antioxidants. Unlike cooking, which can degrade heat-sensitive nutrients like vitamin C and certain B vitamins, eating them raw ensures you receive the maximum benefit. For instance, a 100-gram serving of raw enoki mushrooms provides approximately 30% of the daily recommended intake of vitamin B3 (niacin), which supports energy metabolism and skin health. This makes them an excellent addition to salads, wraps, or as a crunchy garnish.
From an antioxidant perspective, raw enoki mushrooms shine with their high levels of ergothioneine, a compound linked to cellular protection and anti-inflammatory effects. Studies suggest that consuming 50–100 grams of raw enoki mushrooms daily may help combat oxidative stress, a key factor in aging and chronic diseases. Pairing them with vitamin C-rich foods like bell peppers or citrus enhances iron absorption, as enokis are also a good plant-based iron source. This synergy highlights the practical benefits of incorporating them raw into your diet.
For those seeking immune support, raw enoki mushrooms offer beta-glucans, a type of fiber with proven immunomodulatory properties. Research indicates that regular consumption of beta-glucans can stimulate immune cell activity, potentially reducing the risk of infections. A simple way to harness this benefit is by adding a handful of raw enoki mushrooms to smoothies or cold soups, ensuring the beta-glucans remain intact. However, individuals with mushroom allergies or sensitive digestive systems should start with small portions to assess tolerance.
Comparatively, while cooked enoki mushrooms still provide nutritional value, their raw form offers a more concentrated dose of nutrients and bioactive compounds. For example, cooking can reduce the availability of polysaccharides, which are better preserved when eaten raw. This makes raw enokis particularly appealing for health-conscious individuals aiming to maximize nutrient intake with minimal preparation. Incorporating them into raw dishes not only elevates flavor but also amplifies their health-promoting properties.
In practical terms, integrating raw enoki mushrooms into your diet is straightforward. Toss them into green salads for added texture, blend them into vegetable-based dips, or use them as a low-calorie alternative to noodles in raw pad Thai. For optimal freshness, store them in the refrigerator and consume within a week of purchase. By prioritizing raw consumption, you unlock their full nutritional potential, making them a versatile and beneficial addition to any diet.
Can Mushrooms Thrive in Zero Gravity? Exploring Space Fungus Potential
You may want to see also

Safety Concerns: Ensure enoki mushrooms are fresh and clean to avoid potential bacterial or parasitic risks
Enoki mushrooms, with their crisp texture and mild flavor, are a tempting addition to salads and raw dishes. However, their delicate appearance belies a critical need for caution. Raw consumption requires meticulous attention to freshness and cleanliness to mitigate bacterial and parasitic risks. Unlike heartier mushrooms, enokis’ slender structure and high moisture content create an ideal environment for pathogens if not handled properly.
Inspection and Selection: The First Line of Defense
Begin by scrutinizing the mushrooms at purchase. Fresh enokis should appear firm, with no sliminess or discoloration. Avoid clusters with a damp, clammy feel or those packaged in waterlogged containers, as excess moisture accelerates bacterial growth. Opt for refrigerated, tightly sealed packs, and check expiration dates rigorously. Even minor signs of spoilage—such as a sour odor or darkened stems—signal potential contamination.
Cleaning Rituals: Precision Over Aggression
Washing enokis demands a gentle touch. Submerge them briefly in cold water, agitating lightly to dislodge debris. Avoid prolonged soaking, as it dilutes their flavor and increases water absorption, fostering bacterial proliferation. Trim the base of the cluster, where dirt often accumulates, and pat dry with a clean cloth. For added safety, especially if consumed raw, a 30-second rinse in a mild vinegar solution (1 tablespoon per cup of water) can reduce surface bacteria without compromising taste.
Storage Strategies: Time and Temperature Control
Improper storage transforms enokis into a hazard. Refrigerate them unwashed in a paper bag or wrapped in a damp cloth to maintain humidity without trapping moisture. Consume within 3–5 days, as refrigeration slows but does not halt bacterial growth. Freezing is not recommended, as it alters their texture, making them unsuitable for raw use. If in doubt, discard—the risk of foodborne illness outweighs the cost of replacement.
Contextual Cautions: Vulnerable Populations and Preparation
While healthy adults may tolerate minor lapses, immunocompromised individuals, children, and pregnant women face heightened risks. For these groups, lightly cooking enokis (2–3 minutes at 165°F/74°C) eliminates pathogens without sacrificing nutritional value. When serving raw, pair them with acidic ingredients like lemon juice or rice vinegar, which inhibit bacterial growth. Always source enokis from reputable suppliers, as commercial cultivation practices significantly impact safety.
By treating enoki mushrooms with the same vigilance as raw seafood or poultry, you transform a potential hazard into a safe, delightful culinary addition. Freshness, cleanliness, and informed handling are not optional—they are the pillars of raw enoki consumption.
Freezing Sautéed Mushrooms and Onions: A Handy Kitchen Tip
You may want to see also

Texture & Taste: Raw enoki has a crisp texture and mild flavor, ideal for salads or garnishes
Raw enoki mushrooms offer a unique sensory experience, particularly when consumed uncooked. Their crisp texture provides a satisfying snap with each bite, akin to that of a fresh snap pea or a thinly sliced radish. This quality makes them an excellent addition to dishes where a textural contrast is desired. Unlike their cooked counterparts, which soften and take on a more delicate, almost silky consistency, raw enoki mushrooms retain their structural integrity, adding a refreshing crunch to any meal.
The mild flavor of raw enoki mushrooms is another attribute that sets them apart. Their taste is subtle, with hints of earthiness that complement rather than overpower other ingredients. This neutrality allows them to blend seamlessly into a variety of dishes, from vibrant salads to elegant garnishes. For instance, tossing a handful of raw enoki mushrooms into a mixed green salad can introduce an interesting texture without altering the overall flavor profile. Similarly, using them as a garnish on top of soups or stir-fries adds a visual and tactile element that enhances the dining experience.
Incorporating raw enoki mushrooms into your diet is straightforward, but there are a few practical tips to maximize their appeal. First, ensure the mushrooms are thoroughly cleaned by gently rinsing them under cold water and patting them dry with a paper towel. Their delicate nature requires a light touch to avoid damage. Second, consider pairing them with ingredients that highlight their crispness, such as crisp lettuce, cucumber, or bell peppers. For a simple yet elegant dish, try a raw enoki mushroom salad with a light vinaigrette made from olive oil, lemon juice, and a pinch of salt.
While raw enoki mushrooms are generally safe to eat, it’s important to source them from reputable suppliers to avoid potential contaminants. Always inspect the mushrooms for any signs of spoilage, such as sliminess or discoloration, before consumption. For those with sensitive digestive systems, start with small portions to gauge tolerance, as raw mushrooms can sometimes be harder to digest than their cooked counterparts. However, when prepared and consumed mindfully, raw enoki mushrooms can be a delightful and healthful addition to your culinary repertoire.
Finally, the versatility of raw enoki mushrooms extends beyond salads and garnishes. They can be used in wraps, sandwiches, or even as a topping for avocado toast, adding a unique texture and a subtle earthy note. For a creative twist, marinate them in a mixture of soy sauce, sesame oil, and garlic for 10–15 minutes before serving. This brief marination enhances their flavor without compromising their crispness, making them a standout ingredient in any dish. Whether you’re a seasoned chef or a home cook, raw enoki mushrooms offer a simple yet effective way to elevate your meals.
Can Touching Mushrooms Trigger Allergic Reactions? What You Need to Know
You may want to see also
Explore related products

Preparation Tips: Rinse thoroughly, trim ends, and pat dry before adding to raw dishes
Enoki mushrooms, with their delicate texture and mild flavor, are a versatile ingredient that can be enjoyed raw, but proper preparation is key to ensuring both safety and optimal taste. The first step in preparing raw enoki mushrooms is to rinse them thoroughly. Unlike heartier mushrooms, enokis are grown in controlled environments but can still carry residual soil or debris. Hold them gently under cold running water, using your fingers to separate the clusters and allow water to flow through. Avoid soaking them, as their thin structure can absorb excess moisture, diluting their flavor and causing sogginess in raw dishes.
After rinsing, trimming the ends is essential. The base of enoki clusters often includes a tough, fibrous portion where the mushrooms were attached to the growing medium. Use a sharp knife or kitchen shears to remove approximately 1–2 centimeters from the bottom. This step not only improves texture but also eliminates any potential bitterness or off-flavors that can linger in the stem bases. For precision, trim just enough to remove the hardened area without sacrificing too much of the edible portion.
Once rinsed and trimmed, patting the mushrooms dry is crucial, especially when using them in raw applications like salads, wraps, or garnishes. Excess moisture can water down dressings or sauces and compromise the dish’s overall texture. Lay the enokis on a clean kitchen towel or paper towels and gently blot them dry. Alternatively, use a salad spinner for a quicker, hands-off approach. Ensure they are just damp enough to retain their natural crispness without being wet.
Incorporating raw enoki mushrooms into dishes requires a thoughtful approach to maintain their integrity. After preparation, add them to recipes just before serving to prevent them from wilting or becoming limp. Their slender profile makes them ideal for layering in sandwiches or scattering over grain bowls, while their subtle umami enhances the freshness of raw vegetables. For a simple yet elegant touch, toss them with a light vinaigrette, fresh herbs, and a sprinkle of sesame seeds for added crunch.
While raw enokis are generally safe to consume, proper handling is non-negotiable. Always source them from reputable suppliers and inspect for any signs of spoilage, such as sliminess or discoloration. By following these preparation steps—rinsing, trimming, and drying—you ensure that the mushrooms not only contribute to the dish’s visual appeal but also deliver their signature delicate texture and flavor. Whether used as a focal point or a supporting ingredient, well-prepared raw enoki mushrooms can elevate any dish with their unique charm.
Mushrooms in Chicken Noodle Soup: A Flavorful Twist to Try?
You may want to see also

Cooking vs. Raw: Cooking enhances umami but reduces certain nutrients; raw preserves enzymes and freshness
Enoki mushrooms, with their delicate texture and mild flavor, are a versatile ingredient that can be enjoyed both raw and cooked. However, the choice between these methods significantly impacts their taste, nutritional profile, and culinary applications. Cooking enoki mushrooms amplifies their umami—that savory, deeply satisfying fifth taste—by breaking down proteins and releasing glutamates. This process transforms their subtle flavor into a richer, more complex experience, making them an excellent addition to soups, stir-fries, or sautéed dishes. Yet, heat also diminishes certain heat-sensitive nutrients, such as vitamin C and B vitamins, and deactivates enzymes that aid digestion. Raw enoki mushrooms, on the other hand, retain these nutrients and enzymes, offering a crisp, fresh addition to salads, sandwiches, or as a garnish. The decision to cook or eat them raw ultimately depends on whether you prioritize flavor enhancement or nutritional preservation.
For those seeking to maximize umami, lightly sautéing or simmering enoki mushrooms in broth for 2–3 minutes is ideal. This brief cooking time preserves their tender texture while unlocking their savory potential. Pair them with ingredients like soy sauce, garlic, or miso to further elevate their flavor profile. Conversely, if you’re aiming to retain their nutritional benefits, incorporate raw enoki mushrooms into dishes where their freshness shines. Toss them into a green salad with a light vinaigrette, or use them as a crunchy topping for avocado toast. Their mild taste complements a wide range of ingredients without overpowering the dish.
From a nutritional standpoint, raw enoki mushrooms offer a slight edge due to their preserved enzymes and vitamins. These enzymes can aid in digestion and nutrient absorption, making them particularly beneficial for those with sensitive digestive systems. However, the nutrient loss from cooking is minimal compared to the flavor gained, so occasional cooking won’t significantly impact their health benefits. For example, a 100-gram serving of raw enoki mushrooms contains approximately 0.3 mg of vitamin C, while cooking may reduce this by 10–20%. This trade-off is negligible for most individuals, especially when balanced with the enhanced taste.
Practicality also plays a role in this decision. Raw enoki mushrooms require thorough rinsing to remove any debris or grit, as their long, thin stems can trap particles. Cooking eliminates this concern, as the heat naturally sanitizes the mushrooms. Additionally, cooked enoki mushrooms have a longer shelf life when stored properly, whereas raw mushrooms should be consumed within a few days to maintain their freshness. For busy cooks, this makes cooking a more convenient option.
In conclusion, the choice between raw and cooked enoki mushrooms hinges on your culinary goals. If you’re crafting a dish where umami is key, cooking is the way to go. If freshness and nutrient retention are priorities, enjoy them raw. Both methods offer unique benefits, allowing enoki mushrooms to adapt to a variety of recipes and dietary preferences. Experiment with both to discover which approach best suits your palate and needs.
Portabella Mushrooms and Diarrhea: Unraveling the Digestive Connection
You may want to see also
Frequently asked questions
Yes, enoki mushrooms can be eaten raw. They have a mild, slightly sweet flavor and a crisp texture, making them a popular addition to salads, sandwiches, and other raw dishes.
While enoki mushrooms are generally safe to eat raw, it’s important to ensure they are fresh, clean, and sourced from a reputable supplier. Raw mushrooms can sometimes carry bacteria or parasites, so proper handling and storage are essential.
Raw enoki mushrooms retain their nutritional value, including vitamins, minerals, and antioxidants. However, cooking can make certain nutrients more bioavailable, so both raw and cooked preparations offer health benefits.






















![[KUZE FUKU & SONS] Enoki Mushrooms in Savory Umami Sauce, Multipurpose Rice Topping, Garnish, & Flavoring, Product of Japan (8.4 Oz /240 g)](https://m.media-amazon.com/images/I/515b2HWqy-L._AC_UL320_.jpg)